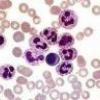
Испанский метод в диагностике болезни Альцгеймера

Новости - Страница 64
Протесты челябинских медиков
2012-01-28 23:57:58
Novartis опубликовал результаты испытаний вакцины против менингококка В
2012-01-28 23:12:32
Номенклатура медицинских услуг утверждена
2012-01-28 07:43:32
Вспышка сальмонеллеза в Иркутской области не повторится
2012-01-27 23:51:43
Птичий грипп приближается к российским туристам
2012-01-27 23:43:32
Испанский метод в диагностике болезни Альцгеймера
2012-01-27 17:32:21
Регулярное употребление грецких орехов замедляет рост рака предстательной железы
2012-01-26 23:43:23
Генетические исследования привлекают интерес крупнейших фармкомпаний
2012-01-26 21:34:20
Анальгетики нового поколения будут иметь целенаправленное действие
2012-01-26 06:45:32
Электронный архив медицинских карт свяжет клиники и больницы Финляндии
2012-01-25 08:31:32